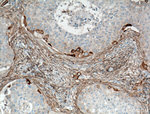
RPL7A Antibody in Immunohistochemistry (Paraffin) (IHC (P))

Search
Proteintech
RPL7A Polyclonal Antibody
{{$productOrderCtrl.translations['antibody.pdp.commerceCard.promotion.promotions']}}
{{$productOrderCtrl.translations['antibody.pdp.commerceCard.promotion.viewpromo']}}
{{$productOrderCtrl.translations['antibody.pdp.commerceCard.promotion.promocode']}}: {{promo.promoCode}} {{promo.promoTitle}} {{promo.promoDescription}}. {{$productOrderCtrl.translations['antibody.pdp.commerceCard.promotion.learnmore']}}
产品信息
15340-1-AP
种属反应
已发表种属
宿主/亚型
分类
类型
抗原
偶联物
形式
浓度
规格
纯化类型
保存液
内含物
保存条件
运输条件
产品详细信息
Immunogen sequence: MPKGKKAKG KKVAPAPAVV KKQEAKKVVN PLFEKRPKNF GIGQDIQPKR DLTRFVKWPR YIRLQRQRAI LYKRLKVPPA INQFTQALDR QTATQLLKLA HKYRPETKQE KKQRLLARAE KKAAGKGDVP TKRPPVLRAG VNTVTTLVEN KKAQLVVIAH DVDPIELVVF LPALCRKMGV PYCIIKGKAR LGRLVHRKTC TTVAFTQVNS EDKGALAKLV EAIRTNYNDR YDEIRRHWGG NVLGPKSVAR IAKLEKAKAK ELATKLG (1-266 aa encoded by BC005128)
靶标信息
Cytoplasmic ribosomes, organelles that catalyze protein synthesis, consist of a small 40S subunit and a large 60S subunit. Together these subunits are composed of 4 RNA species and approximately 80 structurally distinct proteins. This gene encodes a ribosomal protein that is a component of the 60S subunit. The protein belongs to the L7AE family of ribosomal proteins. It can interact with a subclass of nuclear hormone receptors, including thyroid hormone receptor, and inhibit their ability to transactivate by preventing their binding to their DNA response elements. This gene is included in the surfeit gene cluster, a group of very tightly linked genes that do not share sequence similarity. It is co-transcribed with the U24, U36a, U36b, and U36c small nucleolar RNA genes, which are located in its second, fifth, fourth, and sixth introns, respectively. This gene rearranges with the trk proto-oncogene to form the chimeric oncogene trk-2h, which encodes an oncoprotein consisting of the N terminus of ribosomal protein L7a fused to the receptor tyrosine kinase domain of trk. As is typical for genes encoding ribosomal proteins, there are multiple processed pseudogenes of this gene dispersed through the genome.
仅用于科研。不用于诊断过程。未经明确授权不得转售。
生物信息学
蛋白别名: 60S ribosomal protein L7a; Large ribosomal subunit protein eL8; PLA-X polypeptide; ribosomal protein L7a large subunit; surfeit 3; Surfeit locus protein 3; thyroid hormone receptor uncoupling protein; unnamed protein product
基因别名: eL8; L7A; RPL7A; SURF-3; SURF3; TRUP
UniProt ID: (Human) P62424, (Mouse) P12970, (Rat) P62425
Entrez Gene ID: (Human) 6130, (Mouse) 27176, (Rat) 296596